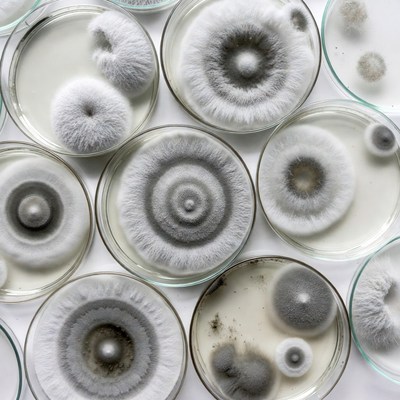
Fungi growth in petri dishes

Free Image:
Colorful microorganisms in a sphere

Like this image:
0Description:
A sphere of various colorful microorganisms, some spherical, some rod-shaped, float in a space filled with a web of glowing lines.
Keywords:
abstract, bacteria, biology, colorful, float, glowing, health, illustration, life, lines, medicine, microorganisms, microscopic, rod-shaped, science, space, sphere, spherical, web, world
Statistics:
| Added: | July 11, 2024 | |
| Views: | 29 | |
| Dimensions: | 1024 x 1024 | |
| Creator: | Kvitka | |
| Image Generator: | Bing |
This image is free to use and available under the Creative Commons CC0 1.0 license.
For more information, please review our Image License.
Disclaimer: This image was generated with AI. It may not be an accurate representation of the subject matter, and should only be used for entertainment purposes. Any likenesses to real people, places or things is purely coincidental.
For more information, please review our Image License.
Disclaimer: This image was generated with AI. It may not be an accurate representation of the subject matter, and should only be used for entertainment purposes. Any likenesses to real people, places or things is purely coincidental.
Results: 1 - 18 of 18 total results